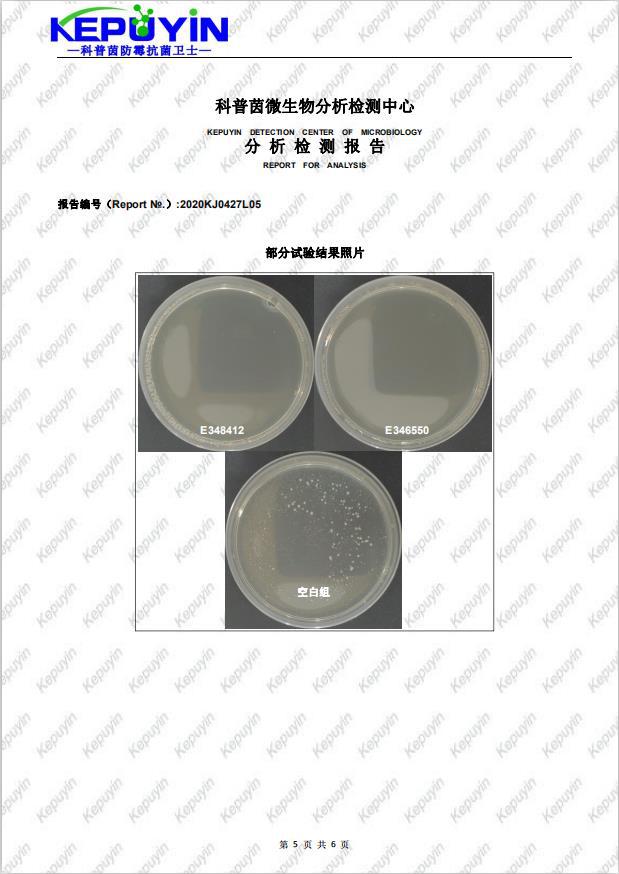
undefined
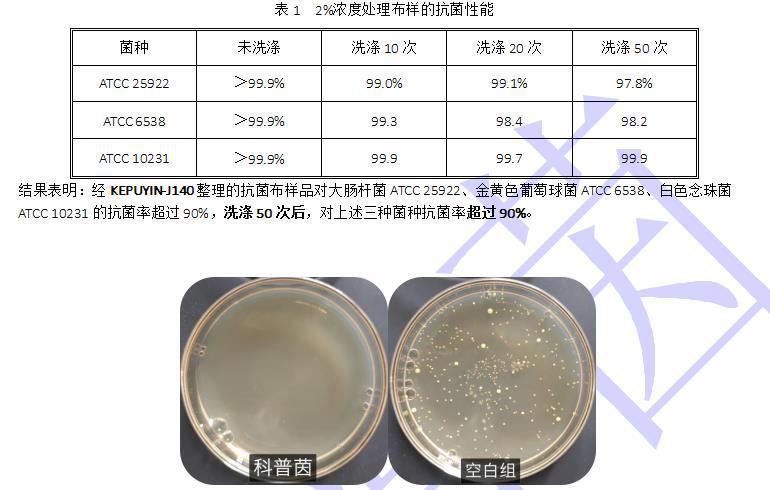
undefined

无刺激纺织抗菌剂 耐洗环保抗菌剂应用与特点
- 供应商
- 佛山科普茵生物科技有限公司
- 认证
- 品牌
- 科普茵
- 型号
- KEPUYIN-J140
- 产地
- 广东
- 联系电话
- 0757-88788686
- 手机号
- 18620907734
- 经理
- 陈师
- 所在地
- 佛山市南海区大沥镇盐步横江横沙路88号厂房的2楼(住所申报)
- 更新时间
- 2021-10-22 10:56


无刺激纺织抗菌剂KEPUYIN-J140,是应用先进安全环保抗菌剂复配而成。该抗菌剂由有多胺基端聚胍类和高活性的季铵盐抗菌剂复配而成,其抗菌效率比一般的聚胍产品高2~3倍;具有极高的安全性,效能持久耐水洗;通过在织物表面的牢固结合,形成持久耐水洗、不迁移的抗菌层,易于加工,适用于绝大部分纺织品种类加工。目前已广泛应用各种天然纺织纤维上。


*对大肠杆菌、金黄色葡萄球菌、白色念珠菌等数百种致病菌都有优异的抗菌作用;
*理化性质稳定,耐高温,耐酸碱,耐紫外线;
*处理后的天然织物具有很强的耐洗涤性,洗涤50次后抗菌率大于90%;
*安全无毒,无刺激性,无致敏性,在自然条件下易降解,不造成污染;
*透明,不改变基体的颜色和其它物理化学性质,应用方便。


运动鞋、休闲鞋、袜子、鞋垫;女士袜子、针织品、贴身内衣裤,男士内衣裤及外套等;床垫、被套、床单、毯子、被罩、填充材料;海绵、发泡材料制品、湿纸巾、抹布;地毡、毛巾、一次性抹布;室内装潢材料、车内饰材料、雨伞、无纺布制品;工作服、制服等等。

◆浸轧法
织物经染色或印花后,用浸轧法可将KEPUYIN-J140施于织物上,高温定型烘干。在处理白色的漂白棉布时,应确保在使用KEPUYIN-J140前,把残余的漂白剂全部去除。织物浸轧抗菌溶液(扎余率70%),140~170℃烘干定型。
用量:KEPUYIN-J140需要用量0.5%-3.0%(O.W.F)。
◆浸渍法
室温下,将织物浸渍在KEPUYIN-J140稀释的水溶液里,KEPUYIN-J140能很快地从稀溶液里吸附到棉布上。在pH=7-8的条件下,吸附量Zui高。浴比为10:1,在40~50℃温度下,浸渍30min。
用量:
耐洗织物抗菌(毛巾、家具罩、衣物)1.0%~2.0%(O.W.F)
废弃织物抗菌(抹布、洗碗布、一次性卫生用品)0.25%~1.0%(O.W.F)
抗真菌(内衣裤、袜)>2% (O.W.F)
备注:先小样试用,确定对处理物无明显改变再进行大批量使用。

无刺激纺织抗菌剂KEPUYIN-J140主要成分作用机理为①胍基具有较高的活性,聚合物成正电性。由于各类细菌、病毒一般呈负电性,所以胍盐很容易被吸附,进而使细菌、病毒无法分裂繁殖,丧失活性;②使细胞膜结构塌陷,形成跨膜气孔,细胞膜破裂,破坏微生物体能量代谢,使细菌病毒丧失活性;③聚合物能形成一层薄膜封闭微生物的呼吸通道,使其窒息。次要成分为双链季铵盐由于分子结构中有两个长链的疏水基团,可以产生协同作用,从而使抗菌性能优于一般的单链季铵盐;同时由于分子中有2个带正电荷的N+离子,诱导作用使得季铵盐上的正电荷密度增加,更有利于吸附在细菌表面,从而影响细胞膜的正常功能,还可干扰细胞核酸和蛋白质的合成,导致细胞死亡。

安全数据
*大白鼠急性经口LD50 >5000mg/kg。急性经皮LD50 >5000mg/kg。
*对皮肤/眼睛无刺激,对黏膜有轻微刺激。
①我国2015年版《化妆品安全技术规范》规定:Zui大使用浓度为0.3%。不适用于可喷雾制剂。
②2016年,欧盟生物杀灭剂产品委员会(BPC)发布法规(EU)2016/125,批准作为PT2、PT3、PT-11生物杀灭剂产品的活性物质。2016年,欧盟生物杀灭剂产品委员会(BPC)发布法规(EU)2016/124,批准作为PT-4生物杀灭剂产品的活性物质批。
测试标准
* AATCC100—2012 纺织材料抗菌整理剂的评定
* AATCC147-2011 纺织品的抗菌性:平行划线法
* ISO20743-2013纺织品家纺产品的抗菌活性的测定
* ISL1902-2015 纤维制品抗菌性试验方法、抗菌效果
* GB/T20944.1-2007 纺织品抗菌性能的评价第1部分:琼脂平皿扩散法
* GB/T20944.2-2007 纺织品抗菌性能的评价第2部分:吸收法
* GB/T20944.3-2008 纺织品抗菌性能的评价第3部分:震荡法
* FZ/T73023-2006(2012) 抗菌针织品

注意事项
本品是高浓度试剂,原液对易过敏者会造成眼睛和皮肤有刺激,使用操作时必须戴手套,避免原液接触皮肤。一旦与皮肤和眼睛接触立即用大量清水及肥皂清洗并及时就医。
包装储存
包装及规格:化工塑料桶包装,25kg/桶。
密封避光储存,储存温度低于30℃。

